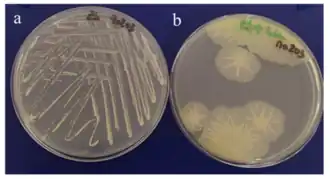
Description de cette image, également commentée ci-après

Alteromonas
| Domaine | Bacteria |
|---|---|
| Embranchement | Pseudomonadota |
| Classe | Gammaproteobacteria |
| Ordre | Alteromonadales |
| Famille | Alteromonadaceae |
Les Alteromonas sont un genre de bactéries marines de la famille Alteromonadaceae. Ce sont des bactéries à Gram négatif, de l'embranchement des Pseudomonadota. L'espèce type de ce genre est Alteromonas macleodii.
Taxonomie
Étymologie
L'étymologie de ce genre est la suivante : Al.te.ro.mo.nas L. pron. alter -tera -terum, autre, différent; L. fem. n. monas, une monade, unité; N.L. fem. n. Alteromonas, une autre Monas [2].
Historique
Le genre Alteromonas a été décrit en sur la base de ses caractéristiques biochimiques et de sa composition en bases nucléotidiques GC avec un pourcentage molaire de 43 à 48%[1]. La famille Alteromonadaceae a été décrite en pour regrouper dans une même famille les genres de Protéobactéries marines Alteromonas, Pseudoalteromonas, Idiomarina et Colwellia sur la base de leurs homologies de séquences ARNr 16S[3], ces espèces forment un clade monophylétique[3]. En , lors de la description de l'ordre Alteromonadales dans le Bergey's Manual, la famille Alteromonadaceae y est intégrée comme unique famille de cet ordre[4] et la même année dans la liste des nouveaux noms n°106 séparée en plusieurs familles[5].
Liste des espèces
Selon la LPSN (11 juillet 2024)[6], le genre Alteromonas compte 36 espèces publiées de manière valide et 6 à 7 espèces publiées de manière non valide.
- Espèces publiées de manière valide
- A. aestuariivivens
- A. alba
- A. alteriprofundi
- A. alterisediminis
- A. antoniana
- A. australica
- A. chungwhensis
- A. confluentis
- A. facilis
- A. flava
- A. fortis
- A. genovensis
- A. gilva
- A. gracilis
- A. halophila
- A. hispanica
- A. iocasae
- A. lipolytica
- A. lipotrueae
- A. lipotrueiana
- A. litorea
- A. lutimaris
- A. macleodii, espèce type
- A. marina
- A. mediterranea
- A. naphthalenivorans
- A. nigrifaciens
- A. oceani
- A. pelagimontana
- A. ponticola
- A. portus
- A. profundi
- A. sediminis
- A. simiduii
- A. stellipolaris
- A. tagae
- Espèces d'Alteromonas publiées de manière non valide, leurs noms reste pour l'instant le nom préféré
- "A. abrolhosensis"
- "A. agarilytica"
- "A. agarilyticus"
- "A. aglvinellae"
- "A. aquimaris"
- "A. arenosi"
- "A. infernus"
- "A. marinoglutinosa"
- "A. marinopraesens"
- "A. oceanisediminis"
- "A. rava"
- "A. salexigens"
- Espèces synonymes mais faisant partie des Alteromonas
- A. addita, synonyme de Alteromonas stellipolaris
- A. indica, synonyme de Alteromonas alterisediminis
- Espèces synonymes désormais dans un autre genre bactérienLes espèces qui ont fait partie des Alteromonas mais qui ont changer de genre bactérien, sont passées dans les genres Pseudoalteromonas, Shewanella, Marinomonas et Oceanospirillum selon LPSN (11 juillet 2024)[6].
- A. atlantica renommée Pseudoalteromonas atlantica en
- A. aurantia renommée Pseudoalteromonas aurantia
- A. carrageenovora renommée Pseudoalteromonas carrageenovora
- A. citrea renommée Pseudoalteromonas citrea
- A. colwelliana renommée Shewanella colwelliana
- A. communis renommée Marinomonas communis
- A. denitrificans renommée Pseudoalteromonas denitrificans
- A. elyakovii renommée Pseudoalteromonas elyakovii
- A. espejiana renommée Pseudoalteromonas espejiana
- A. fuliginea renommée Pseudoalteromonas fuliginea
- A. haloplanktis renommée Pseudoalteromonas haloplanktis
- A. hanedai renommée Shewanella hanedai
- A luteoviolacea renommée Pseudoalteromonas luteoviolacea
- "Alteromonas luteoviolaceus" publiée de manière non valide et renommée Pseudoalteromonas luteoviolacea
- A. putrefaciens renommée Shewanella putrefaciens
- A. rubra renommée Pseudoalteromonas rubra
- A. tetraodonis renommée Pseudoalteromonas tetraodonis
- A. undina renommée Pseudoalteromonas undina
- A. vaga renommée Oceanospirillum vagum
Habitats
Les bactéries du genre Alteromonas sont des bactéries marines[7].
Notes et références
- 1 2 Baumann et al. 1972, p. 418-419.
- ↑ (en) « Genus Alteromonas », sur LPSN,
- 1 2 Ivanova et Mikhailov 2001, p. 15.
- ↑ Bowman et McMeekin 2005, p. 443.
- ↑ (en) Jean Euzéby, « Validation List no. 106. Validation of publication of new names and new combinations previously effectively published outside the IJSEM », International Journal of Systematic and Evolutionary Microbiology, IUMS, vol. 55, , p. 2235–2238 (DOI 10.1099/ijs.0.64108-0)
- 1 2 List of Prokaryotic names with Standing in Nomenclature (LPSN), consulté le 11 juillet 2024.
- ↑ Bowman et McMeekin 2005, p. 446.
Bibliographie
- (en) Linda Baumann, Paul Baumann, M. Mandel et Richard D. Allen, « Taxonomy of Aerobic Marine Eubacteria », Journal of Bacteriology, vol. 110, no 1, , p. 402-429 (DOI 10.1128/jb.110.1.402-429.1972)
- (en) John P. Bowman et Thomas A. McMeekin, « Family I. Alteromonadaceae ord. nov. », dans Brenner Don J., Krieg Noel R., Staley James T., Garrity GM (eds), Bergey's Manual of Systematic Bacteriology, vol. 2 (The Proteobacteria), part B (The Gammaproteobacteria), New York, Springer, , p. 443-444
- (en) John P. Bowman et Thomas A. McMeekin, « Genus I. Alteromonas », dans Don J. Brenner, Noel R. Krieg, James T. Staley, Garrity GM (eds), Bergey's Manual of Systematic Bacteriology, vol. 2 (The Proteobacteria), part B (The Gammaproteobacteria), New York, Springer, , p. 444-447
- (en) E.P. Ivanova et V.V. Mikhailov, « A New Family, Alteromonadaceae fam. nov., Including Marine Proteobacteria of the Genera Alteromonas, Pseudoalteromonas, Idiomarina, and Colwellia », Microbiology, vol. 70, , p. 10–17 (DOI 10.1023/A:1004876301036)
- (ru) E.P. Ivanova et V.V. Mikhailov, « A New Family, Alteromonadaceae fam. nov., Including Marine Proteobacteria of the Genera Alteromonas, Pseudoalteromonas, Idiomarina, and Colwellia », Microbiologiia, vol. 70, , p. 15-23
Liens externes
- Ressources relatives au vivant :
- Ressource relative à la santé :
- Ressource relative à la recherche :
- Portail de la microbiologie